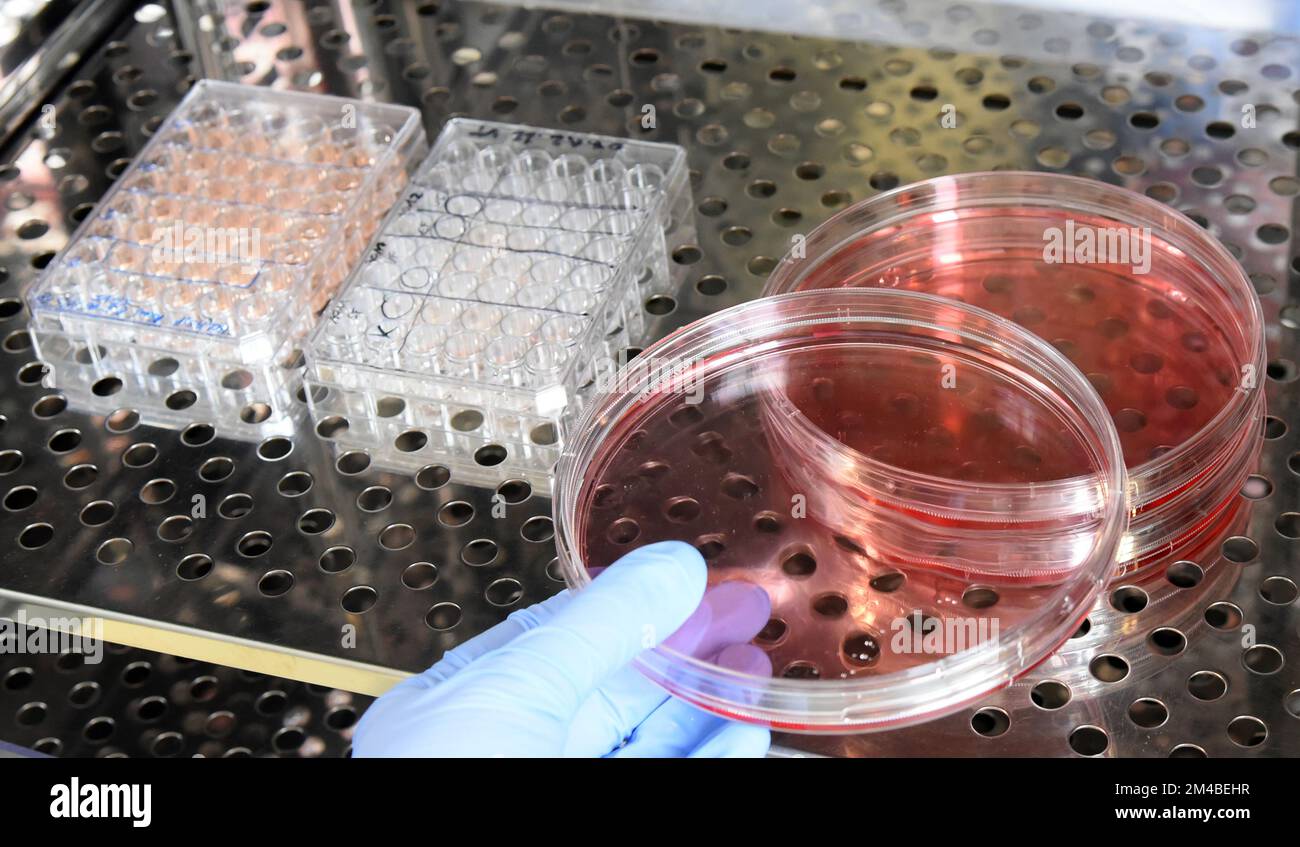
Zellspreizer 5 Stück - Labor Werkzeug Für Mikrobiologie Und Zellkulturen

Hacky Sack Jester - Cord Style Footbag Mit Sandfüllung
Sehr beliebt
lieferbar - in 1-2 Werktagen bei dir
11 €
inkl. MwSt. zzgl.
Versandkosten
Artikelbeschreibung
Aus strapazierfähigem Cord-Stoff mit 12 Feldern - das gibt ihm die perfekte Form für alle möglichen Tricks. Und mit Sand gefüllt fliegt er genau richtig, nicht zu schwer, nicht zu leicht.
Durchmesser 5,7 cm - passt perfekt in jede Tasche. Einfach einstecken und überall mitnehmen: Park, Strand, Schulhof, Büropause...
Warum Hacky Sack so cool ist: • Macht süchtig • Trainiert Koordination • Entspannt den Kopf • Kann man überall spielen • Für alle Altersgruppen
Egal ob alleine oder mit Freunden - du wirst sehen, wie schnell alle mitmachen wollen! Einfach in die Luft kicken und nicht den Boden berühren lassen. Klingt easy, ist aber ganz schön tricky!
Hergestellt in Pakistan oder Guatemala - da wo sie's wirklich können! Die Qualität ist genau wie in den besten Sportgeschäften, nur viel günstiger.
Farben können etwas variieren - das macht jedes Stück einzigartig! Also schnapp dir einen und werd zum Hacky Sack-Profi! Deine Füße werden's dir danken.